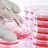
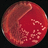

cdhfinechemical
shares
CDH is one of the leading manufacturer company that offers various high quality of electronic grade chemicals and ion pair chromatography. @ Ion Pair Chromatography, Electronic Grade Chemicals, Ion Pair Che... 
cdhfinechemical
shares
CDH- Central Drug House (P) Ltd. Is one of the leading company that provides laboratory chemicals, dehydrated culture media and organic lab chemical. @ CDH- Laboratory Chemicals India, Fine Chemicals, Biological Stain... 
cdhfinechemical
shares
We are one of the leading manufacturer and supplier organization in India that offers a superior quality range of yeast extract powder. @ Yeast Extract Powder India,Yeast Extract Powder Manufacturer & Su... 
cdhfinechemical
shares
We are a manufacturer and supplier organizations in India that offers high quality of various kinds of culture media and many more. @ Culture Media, Cell Culture Media, Culture Media Bases
cdhfinechemical
shares
We are one of the best innovative producers of high purity solvents improved form of column chromatography. @ High Purity Solvents, HPLC Solvents, Acetonitrile HPLC 
cdhfinechemical
shares
CDH- Central Drug House Pvt. Ltd is an ISO 9001: 2008 certified world's most companies in India. @ About CDH- Central Drug House
cdhfinechemical
shares
We are microgen media based certified company and we developing a superior quality range of products based in India. @ Microgen, Microgen Media, Label Specimen Microgen 
cdhfinechemical
shares
Nutrient Agar Media Supplier in India @ Nutrient Agar India, Nutrient Agar Media, Nutrient Agar Suppliers
cdhfinechemical
shares
CDH is one of the leading company that provides a superior quality range of plant tissue culture media and different type culture media products, @ Plant Tissue Culture Media, Prepared Culture Media, Tissue Cultur... 
cdhfinechemical
shares
Laboratory Cleaning Agents - Central Drug House Pvt. Ltd @ Chemicals Supplier India, Chemical Lab Supply, Laboratory Cleanin...